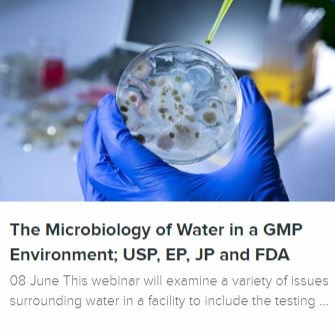

Knowledge of the microbiology of water in a GMP environment is critical to the health of any water system being used to produce a pharmaceutical or biotechnology product. Even companies manufacturing tablets need to be aware of the quality of the water that may be contacting their process or product. The well-being of a facility revolves around the health of each water system within that facility. How often have we learned of a facility being closed for weeks at a time because of a water system that has exceeded its microbiological specifications?
This live, interactive WCS training webinar presentation will also examine a variety of the issues surrounding water in a facility to include the testing of each water source and to what extent. It will cover testing requirements during commissioning and testing on an on-going basis. The webinar will examine Quality Risk Management (ICH Q9) and discuss how a properly developed Facility Water Validation Plan may lead to a logical, reduced requirement for testing vs. time.
The presentation will explore the time requirement for testing before reduced testing might occur and why some organizations refuse to accept this path.
The objective of this live and interactive WCS webinar is to assist those involved in the development of a process or the manufacturing of a product to explore water, as a raw material (component) in a GMP environment, the requirements for potable water, purified water, water for injection and steam to assure that they are meeting the current USP, EP, JP and FDA requirements. Please plan to have a Project team attend to gain the most from this webinar.
Webinar Takeaway
This live, interactive WCS training webinar presentation will also examine a variety of the issues surrounding water in a facility to include the testing of each water source and to what extent. It will cover testing requirements during commissioning and testing on an on-going basis. The webinar will examine Quality Risk Management (ICH Q9) and discuss how a properly developed Facility Water Validation Plan may lead to a logical, reduced requirement for testing vs. time.
The presentation will explore the time requirement for testing before reduced testing might occur and why some organizations refuse to accept this path.
The objective of this live and interactive WCS webinar is to assist those involved in the development of a process or the manufacturing of a product to explore water, as a raw material (component) in a GMP environment, the requirements for potable water, purified water, water for injection and steam to assure that they are meeting the current USP, EP, JP and FDA requirements. Please plan to have a Project team attend to gain the most from this webinar.
Webinar Takeaway
- How to set up a water sampling system and its test frequency.
- Determining the “Health” of a water system based upon test results.
- What are the differences between USP, EP and JP water requirements
- The use of Alert and Action Levels vs. Specifications and what is meant by each.
- When should microorganisms be identified and the preferred methods.
- Understanding the requirements for in-house vs. purchased water.
- Determination of various validations that supplement the maintenance of a USP Purified Water or Water for Injection system.
- How to diagnose and control a water system problem.
Who Will Benefit
The following individuals or disciplines will benefit from attending this Webinar:
- Facilities
- Manufacturing
- Product Development
- Project Management
- Quality Assurance
- Quality Control
- Regulatory Affairs
- Regulatory Compliance
Speaker
Barry A. Friedman (30 Year of Exp.)
Ph.D. at The Ohio State University
Sarasota, Florida
Barry A. Friedman, Ph.D., is a Senior Consultant in the Biotechnology, Regulatory Compliance, Microbiology and Aseptic Processing arena. From 2000 to 2007, Dr. Friedman was associated with Cambrex Bio Science Baltimore, a contract manufacturer of GMP bulk biopharmaceuticals located in Baltimore, MD. In that capacity as the Director, Quality Control, he managed a multi-shift Department of thirty one individuals involved in Client management, the receipt and testing of raw materials, environmental monitoring and microbiology, analytical chemistry and QC compliance for the production of Phase 1, 2, 3 and commercial products manufactured from bacteria, yeast and mammalian cells.
Barry A. Friedman (30 Year of Exp.)
Ph.D. at The Ohio State University
Sarasota, Florida
Barry A. Friedman, Ph.D., is a Senior Consultant in the Biotechnology, Regulatory Compliance, Microbiology and Aseptic Processing arena. From 2000 to 2007, Dr. Friedman was associated with Cambrex Bio Science Baltimore, a contract manufacturer of GMP bulk biopharmaceuticals located in Baltimore, MD. In that capacity as the Director, Quality Control, he managed a multi-shift Department of thirty one individuals involved in Client management, the receipt and testing of raw materials, environmental monitoring and microbiology, analytical chemistry and QC compliance for the production of Phase 1, 2, 3 and commercial products manufactured from bacteria, yeast and mammalian cells.